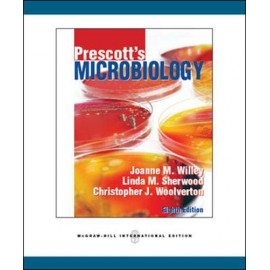

MICROBIOLOGY
Sidebar
Grid View:
APPLIED INFORMATION TECHNOLOGY FOR THE LABORATORY
KSh.1,000.00
APPLIED INFORMATION TECHNOLOGY FOR THE LABORATORY..
DISTRICT LABORATORY PRACTICE IN TROPICAL COUNTRIES part 1
KSh.8,100.00
DISTRICT LABORATORY PRACTICE IN TROPICAL COUNTRIES part 1..
DISTRICT LABORATORY PRACTICE IN TROPICAL COUNTRIES part 2
KSh.8,100.00
DISTRICT LABORATORY PRACTICE IN TROPICAL COUNTRIES part 2..
Medical Microbiology for Nurses: Including Parasitology
KSh.7,040.00
Medical Microbiology for Nurses: Including Parasitology..
MICROBIOLOGY FOR NURSING & ALLIED SCIENCES
KSh.1,000.00
MICROBIOLOGY FOR NURSING & ALLIED SCIENCES..
Showing 1 to 14 of 14 (1 Pages)